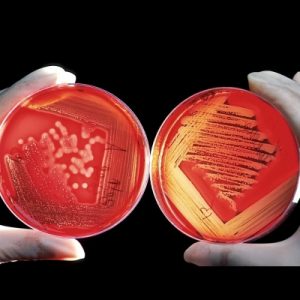
Anti-infectives-430-px-300x300

ABOUT US
We are an Indian pharmaceutical organisation, with a special focus on critical care segment. We draw inspiration from the great Greek physician "Galen" who had tremendous expertise in anatomy, surgery, pharmacology and therapeutic methods. He was a driving force that led to the development of various branches of medicine like anatomy, physiology, neurology etc. We also envisage to develop key milestones to bring innovative medicines and technologies for healthcare professionals and patients..
OURSERVICES
Demand first-rate Best services
Our mission is to provide quality English language instruction through a variety of courses to international

Web Design
Development

Branding

Cloud Service

Marketing
PRODUCTS
Experienced in gallery
OURTEAM
Committed to team excellence
OUR price plan
Live Chat 24/7 support
Our Mission Is To Provide Quality English Language Instruction Through A Variety Of Courses To International
Designing ALL DESIGNS
17/Month
Creative Design Enable
Vibrant Color Usage
Eye Catching Design
Extreme Typography
Exceptional Design
Development PRODUCT
17/Month
Creative Design Enable
Vibrant Color Usage
Eye Catching Design
Extreme Typography
Exceptional Design
optimize & seo PRODUCT
17/Month
Creative Design Enable
Vibrant Color Usage
Eye Catching Design
Extreme Typography
Exceptional Design
OURPEOPLE
We are a people centric organization, making growth and welfare of our team a priority.

Our mission is to provide quality English language instruction through a variety of courses to international and local students in a professional and supportive atmosphere utilizing our unique English teaching methodology.Our mission is to provide.

Integrity
- Trusted Healthcare Solutions
- Transparency in operations
- Patient Centric

Innovation
- Agility in bridging healthcare gaps
- Creative approach
- Cutting Edge Solutions

Sustainable
- Sustainable Collaborations
- Considerate to environmental impact
- Ethical

Accountability
- Solution Driven
- Swift Decision Making
- Eye for Perfection
Happy Clients
Our mission is to provide quality
User Customers
English Language Instruction.
Years Exprience
Our mission is to provide quality
OURBLOG
The premier source for everything blog
Our Mission Is To Provide Quality English Language Instruction Through A Variety Of Courses To International And Local Students.